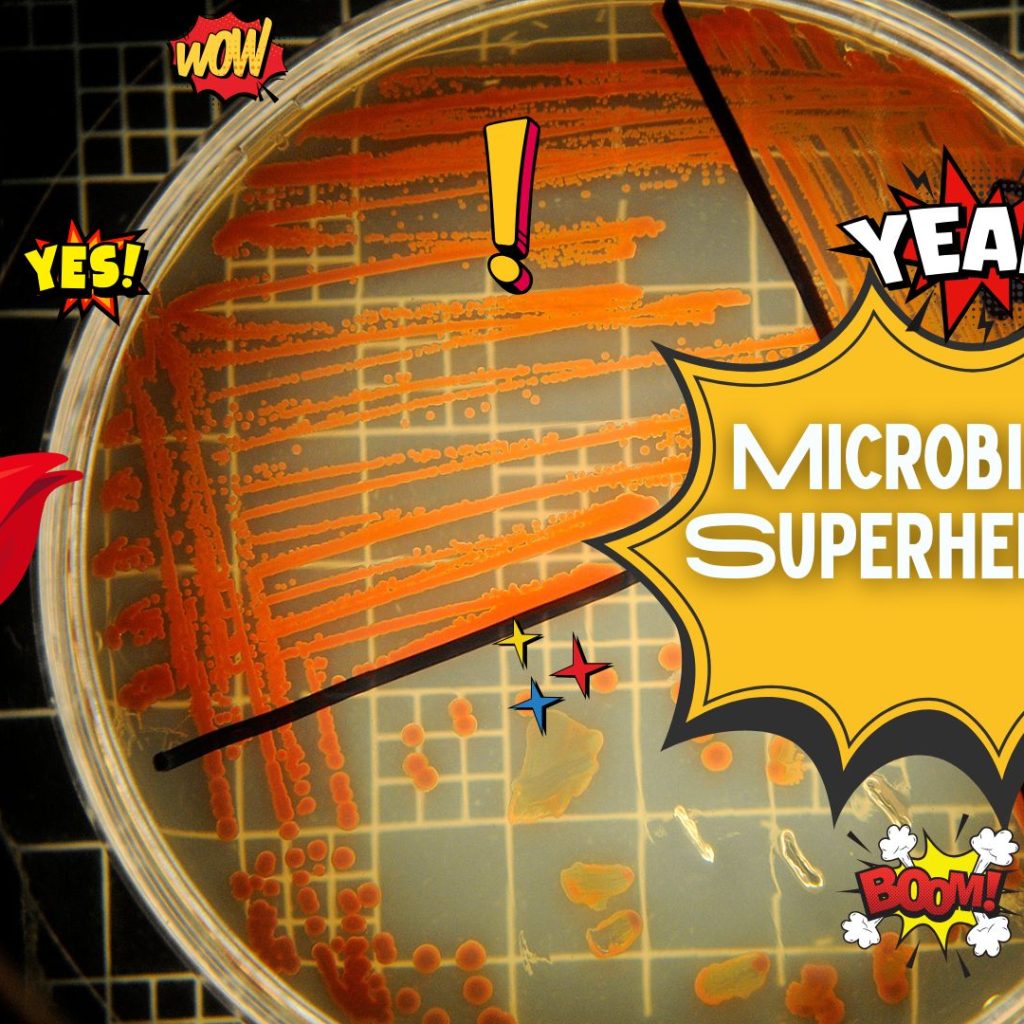

Outbreak | HON 312 North Carolina State University Honors Program. Redesigned Spring 2023. Website: go.ncsu.edu/outbreak
Microbial Superheroes | LSC 170 | North Carolina State University Department of Biological Sciences. Website: go.ncsu.edu/delftiabook

Portable Genome Sequencing | BIT 495/595 | North Carolina State Biotechnology Program.

Metagenomics | BIT 477/577 | North Carolina State University Biotechnology Program. Website: go.ncsu.edu/bitmetagenomics

Portable Genome Sequencing | BIT 495/595 | North Carolina State Biotechnology Program.

High-throughput Discovery | BIT 479/579 | North Carolina State University Biotechnology Program. Website: go.ncsu.edu/htd

Biotechnology & Sustainability | BIT 295| North Carolina State University Biotechnology Program. Launched Spring 2022. Website: go.ncsu.edu/bits
Other Courses Taught
- Metabolic Modeling | BIT 495/595 North Carolina State University Biotechnology Program. Launched Spring 2022. Website: go.ncsu.edu/metmod
- Open Education Resources and Pedagogies | OPEN 9200 Kwantlen Polytechnic University Continuing and Professional Studies. Fall 2022.